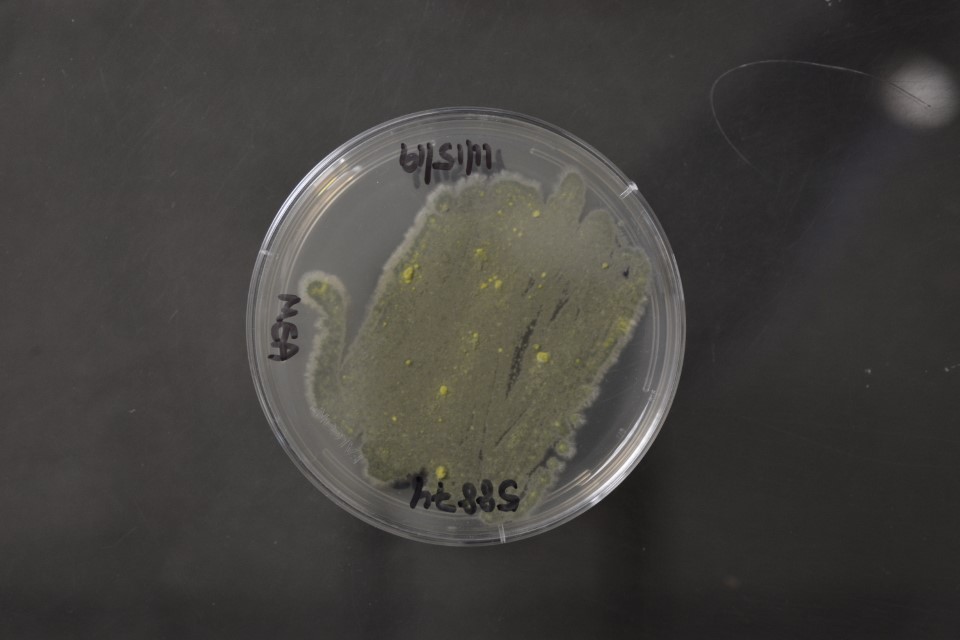
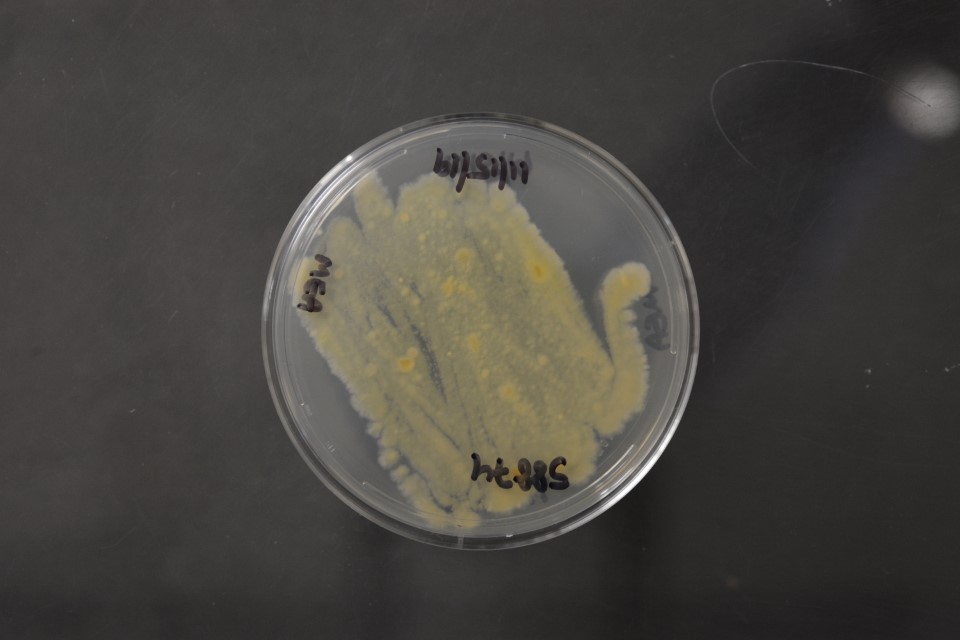

Talaromyces delawarensis
NRRL 58874(Type Strain)
Accession numbers in other collections:999=CBS 146294
Source:Zeljko Jurjevic,EMSL Analytical,Inc.107 Haddon Avenue Westmont,NJ
Isolated from(substrate):Air,November 2008
Substrate location:New Jersey,USA
Growth media:Malt Extract Agar(number 5)
Optimum growth temperature:25C
Strain images:
NRRL_58874_5_reverse.JPG

NRRL_58874_5_top.JPG
 Comments:Talaromyces sect.islandici
Comments:Talaromyces sect.islandici
NRRL58874